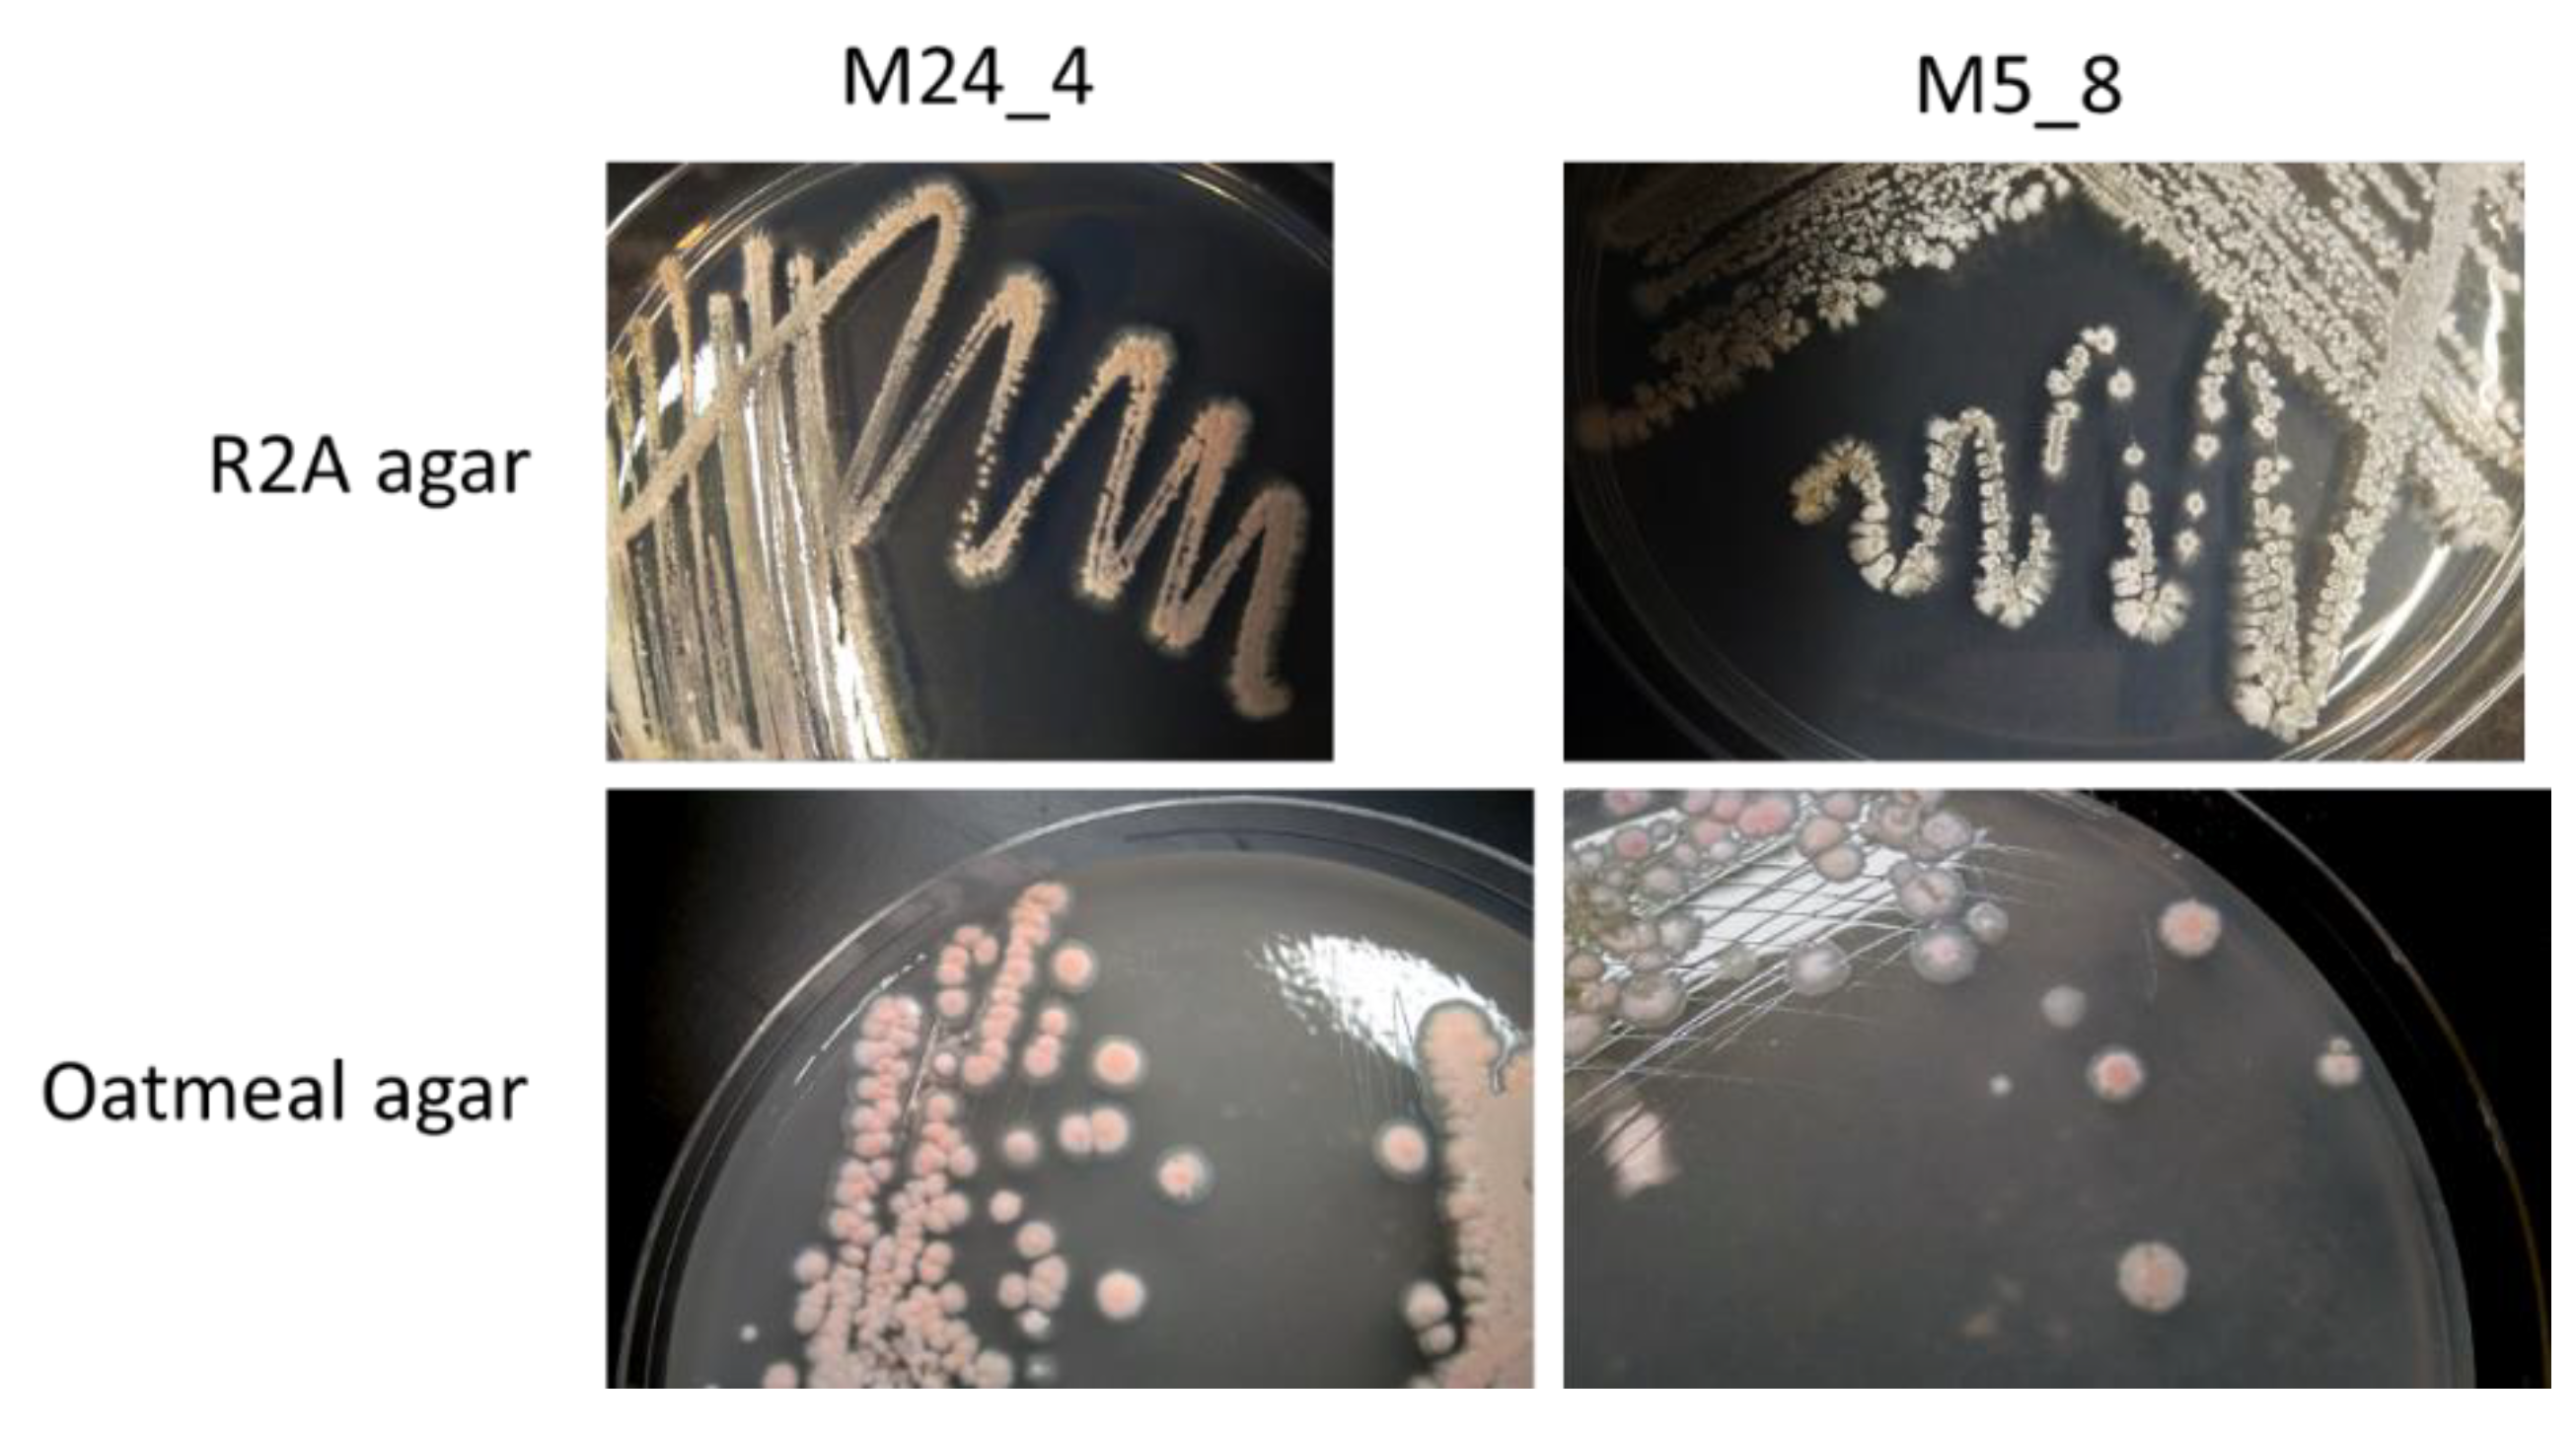
Msf 12 00007 g002

Antimicrobial Activities of Compounds Produced by Newly Isolated Streptomyces Strains from Mountain Caves †
Abstract
:1. Introduction
2. Materials and Methods
2.1. Bacetrial Strains and Grotwh Conditions
2.2. Antimicrobial Activities of Actinobacterial Strains
2.3. Biofilm Analysis
3. Results
4. Discussion
Author Contributions
Funding
Institutional Review Board Statement
Informed Consent Statement
Data Availability Statement
Conflicts of Interest
References
- Korzybski, T.; Kowszyk-Gindifer, Z.; Kurylowicz, W. Antibiotics: Origin, Nature and Properties; Elsevier: Amsterdam, The Netherlands, 1967. [Google Scholar]
- Sass, P. Antibiotics: Methods and Protocols; Springer: Berlin/Heidelberg, Germany, 2016. [Google Scholar]
- Morehead, M.S.; Scarbrough, C. Emergence of Global Antibiotic Resistance. Prim. Care 2018, 45, 467–484. [Google Scholar] [CrossRef] [PubMed]
- Aslam, B.; Wang, W.; Arshad, M.I.; Khurshid, M.; Muzammil, S.; Rasool, M.H.; Nisar, M.A.; Alvi, R.F.; Aslam, M.A.; Qamar, M.U.; et al. Antibiotic Resistance: A Rundown of a Global Crisis. Infect. Drug Resist. 2018, 11, 1645–1658. [Google Scholar] [CrossRef] [PubMed]
- Bragg, R.R.; Meyburgh, C.M.; Lee, J.-Y.; Coetzee, M. Potential Treatment Options in a Post-Antibiotic Era. Adv. Exp. Med. Biol. 2018, 1052, 51–61. [Google Scholar] [CrossRef] [PubMed]
- Cyske, Z.; Jaroszewicz, W.; Żabińska, M.; Lorenc, P.; Sochocka, M.; Bielańska, P.; Grabowski, Ł.; Gaffke, L.; Pierzynowska, K.; Węgrzyn, G. Unexplored potential: Biologically active compounds produced by microorganisms from hard-to-reach environments and their applications. Acta Biochim. Pol. 2021, 68, 565–574. [Google Scholar] [CrossRef] [PubMed]
- Zada, S.; Sajjad, W.; Rafiq, M.; Ali, S.; Hu, Z.; Wang, H.; Cai, R. Cave Microbes as a Potential Source of Drugs Development in the Modern Era. Microb. Ecol. 2021, 25, 1–14. [Google Scholar] [CrossRef]
- Kosznik-Kwaśnicka, K.; Golec, P.; Jaroszewicz, W.; Lubomska, D.; Piechowicz, L. Into the Unknown: Microbial Communities in Caves, Their Role, and Potential Use. Microorganisms 2022, 10, 222. [Google Scholar] [CrossRef] [PubMed]
- Farda, B.; Djebaili, R.; Vaccarelli, I.; Del Gallo, M.; Pellegrini, M. Actinomycetes from Caves: An Overview of Their Diversity, Biotechnological Properties, and Insights for Their Use in Soil Environments. Microorganisms 2022, 10, 453. [Google Scholar] [CrossRef]
- Iquebal, M.A.; Passari, A.K.; Jagannadham, J.; Ahmad, F.; Leo, V.V.; Singh, G.; Jaiswal, S.; Rai, A.; Kumar, D.; Singh, B.P. Microbiome of Pukzing Cave in India shows high antimicrobial activity against plant and animal pathogens. Genomics 2021, 113, 4098–4108. [Google Scholar] [CrossRef]
- Jaroszewicz, W.; Bielańska, P.; Lubomska, D.; Kosznik-Kwaśnicka, K.; Golec, P.; Grabowski, Ł.; Wieczerzak, E.; Dróżdż, W.; Gaffke, L.; Pierzynowska, K.; et al. Antibacterial, Antifungal and Anticancer Activities of Compounds Produced by Newly Isolated Streptomyces Strains from the Szczelina Chochołowska Cave (Tatra Mountains, Poland). Antibiotics 2021, 10, 1212. [Google Scholar] [CrossRef] [PubMed]
- Topka-Bielecka, G.; Bloch, S.; Nejman-Faleńczyk, B.; Grabski, M.; Jurczak-Kurek, A.; Górniak, M.; Dydecka, A.; Necel, A.; Węgrzyn, G.; Węgrzyn, A. Characterization of the Bacteriophage vB_EfaS-271 Infecting Enterococcus faecalis. Int. J. Mol. Sci. 2020, 21, 6345. [Google Scholar] [CrossRef] [PubMed]

| Isolate/Strain | Organism |
|---|---|
| JHARAB1_N | Arthrobacter sp. strain VTT E-052904 |
| JHARN2 | Rhodococcus sp. strain UFZ-B528 |
| JSZCO2 | Microbacterium sp. strain JSZCO2 |
| JSZCZL7 | Nocardia sp. strain JSZCL7 |
| M1_4 | Nocardia sp. strain OAct 132 |
| M1_7 | Arthrobacter sp. strain 3S-5 |
| M1_9 | Tomitella biformata strain AHU 1821 |
| M2_1 | Arthrobacter sp. (uncultured clone) |
| M2_11 | Frigoribacterium sp. strain FB3 |
| M2_15 | Rhodococcus jialingiae strain djl-6-2 16S |
| M2_4 | Arthrobacter sp. strainRKS6-4 |
| M2_9 | Streptomyces sp. strain MM56 |
| M3_10 | Streptomyces sp. strain MM56 |
| M3_8 | Arthrobacter sp. strain 3S-5 |
| M3_9 | Arthrobacter sp. strain MNPB6 |
| M4_18 | Rhodococcus maanshanensis strain GMC121 |
| M4_21 | Arthrobacter sp. strain EM0174 |
| M4_24 | Streptomyces sp. strain MM56 |
| M4_9 | Nocardiopsis umidischolae strain NBRC 100349 |
| M5_2 | Nocardia sp. strain OAct 132 |
| M5_6 | Nocardia sp. strain OAct 132 |
| M5_8 | Streptomyces sp. strain MM56 |
| M5_9 | Streptomyces sp. strain MM56 |
| W2_1 | Microbacterium phyllosphaerae IHBB 11136 |
| Species 1 | Fraction of Strains Sensitive to Contact with Isolated Streptomyces Strains (%) 2 | |
|---|---|---|
| M4_24 | M5_8 | |
| Candida spp. | 76 | 35 |
| Escherichia coli | 100 | 100 |
| Pseudomonas aeruginosa | 100 | 100 |
| Salmonella enterica | 81 | 48 |
| Staphylococcus aureus | 94 | 72 |
Publisher’s Note: MDPI stays neutral with regard to jurisdictional claims in published maps and institutional affiliations. |
© 2022 by the authors. Licensee MDPI, Basel, Switzerland. This article is an open access article distributed under the terms and conditions of the Creative Commons Attribution (CC BY) license (https://creativecommons.org/licenses/by/4.0/).
Share and Cite
Jaroszewicz, W.; Bielańska, P.; Lubomska, D.; Kosznik-Kwaśnicka, K.; Golec, P.; Grabowski, Ł.; Wieczerzak, E.; Dróżdż, W.; Gaffke, L.; Pierzynowska, K.; et al. Antimicrobial Activities of Compounds Produced by Newly Isolated Streptomyces Strains from Mountain Caves. Med. Sci. Forum 2022, 12, 7. https://doi.org/10.3390/eca2022-12749
Jaroszewicz W, Bielańska P, Lubomska D, Kosznik-Kwaśnicka K, Golec P, Grabowski Ł, Wieczerzak E, Dróżdż W, Gaffke L, Pierzynowska K, et al. Antimicrobial Activities of Compounds Produced by Newly Isolated Streptomyces Strains from Mountain Caves. Medical Sciences Forum. 2022; 12(1):7. https://doi.org/10.3390/eca2022-12749
Chicago/Turabian StyleJaroszewicz, Weronika, Patrycja Bielańska, Daria Lubomska, Katarzyna Kosznik-Kwaśnicka, Piotr Golec, Łukasz Grabowski, Ewa Wieczerzak, Weronika Dróżdż, Lidia Gaffke, Karolina Pierzynowska, and et al. 2022. "Antimicrobial Activities of Compounds Produced by Newly Isolated Streptomyces Strains from Mountain Caves" Medical Sciences Forum 12, no. 1: 7. https://doi.org/10.3390/eca2022-12749
APA StyleJaroszewicz, W., Bielańska, P., Lubomska, D., Kosznik-Kwaśnicka, K., Golec, P., Grabowski, Ł., Wieczerzak, E., Dróżdż, W., Gaffke, L., Pierzynowska, K., Cyske, Z., Węgrzyn, A., & Węgrzyn, G. (2022). Antimicrobial Activities of Compounds Produced by Newly Isolated Streptomyces Strains from Mountain Caves. Medical Sciences Forum, 12(1), 7. https://doi.org/10.3390/eca2022-12749

